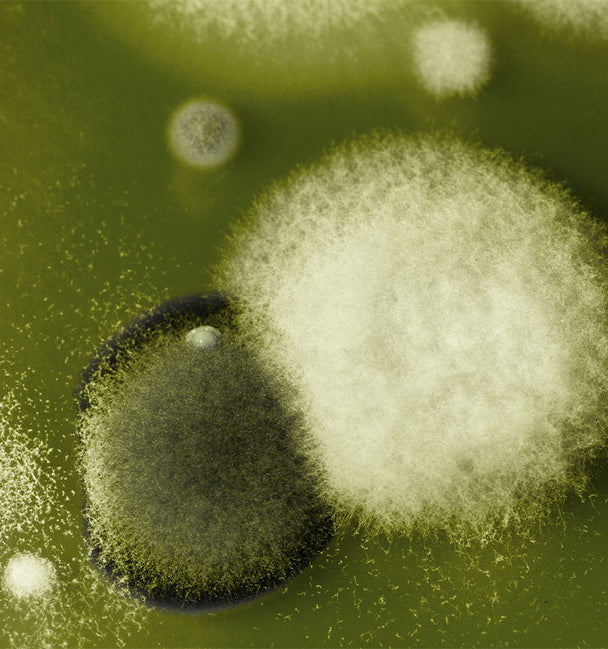

cellular oil
Skin Revival Serum
the powerhouse elixir that activates the skin's energy cycles
Energy is the essence of vibrant skin, and cellular oil supercharges it like nothing else. This formidable serum-in-oil blends the pinnacle of cellular biotechnology with the ethos of luxury, activating your skin's bioelectricity to boost vitality and luminosity.
Enriched with biomimetic lipids derived from wild olive stem cells, cellular oil has been clinically proven to enhance cellular energy by a staggering 98%, optimizing skin’s resilience and regenerative capabilities. Boasting 44% organic ingredients, this formula marries a medley of Mediterranean oils—olive, hazelnut, sweet almond—to nourish the skin barrier while maintaining a non-greasy finish.
Its sumptuous texture and proprietary "Beautifulness" Aromachological blend of gurjum, palo santo, Texas cedar, myrrh, Roman chamomile, rosemary and buchu transform each application into a sublime sensory ritual.
From the first touch, cellular oil speaks of luxury, effectiveness and a profound respect for nature, promising the rejuvenation and reinvention of the beauty ritual.
INNOVATION
INGREDIENTS
BENEFITS
APPLICATION
Choose options





KEY INGREDIENTS
Every ingredient matters.
Every drop distills excellence.

EVIDENCE
clinically proven results in multiple dimensions
Sensory Ritual
BEAUTY THAT CONNECTS

1
Prepare the Skin & Activate the Formula
Start with clean skin to optimize absorption and maximize the treatment’s efficacy. Warm a few drops of cellular oil between your hands by rubbing them together gently — this enhances its bio-affinity with the skin.

2
Awaken the Senses
Bring your palms close to your nose and take several deep inhalations. This simple yet powerful step releases active aromatic molecules, awakening the senses and preparing the skin energetically.

3
Three-Step Application
With a calm mind, gently press both hands onto your face following a natural rhythm:
- First on the cheeks,
- Then on the forehead and neck,
- Finish with soft touches on the décolletage.

4
Complete the Ritual
Apply your preferred treatment cream to seal in moisture and enhance the serum's effects. Cellular oil can be used alone or layered under other products, depending on your skin’s needs.
Discover the “I LOVE YOU” technique.